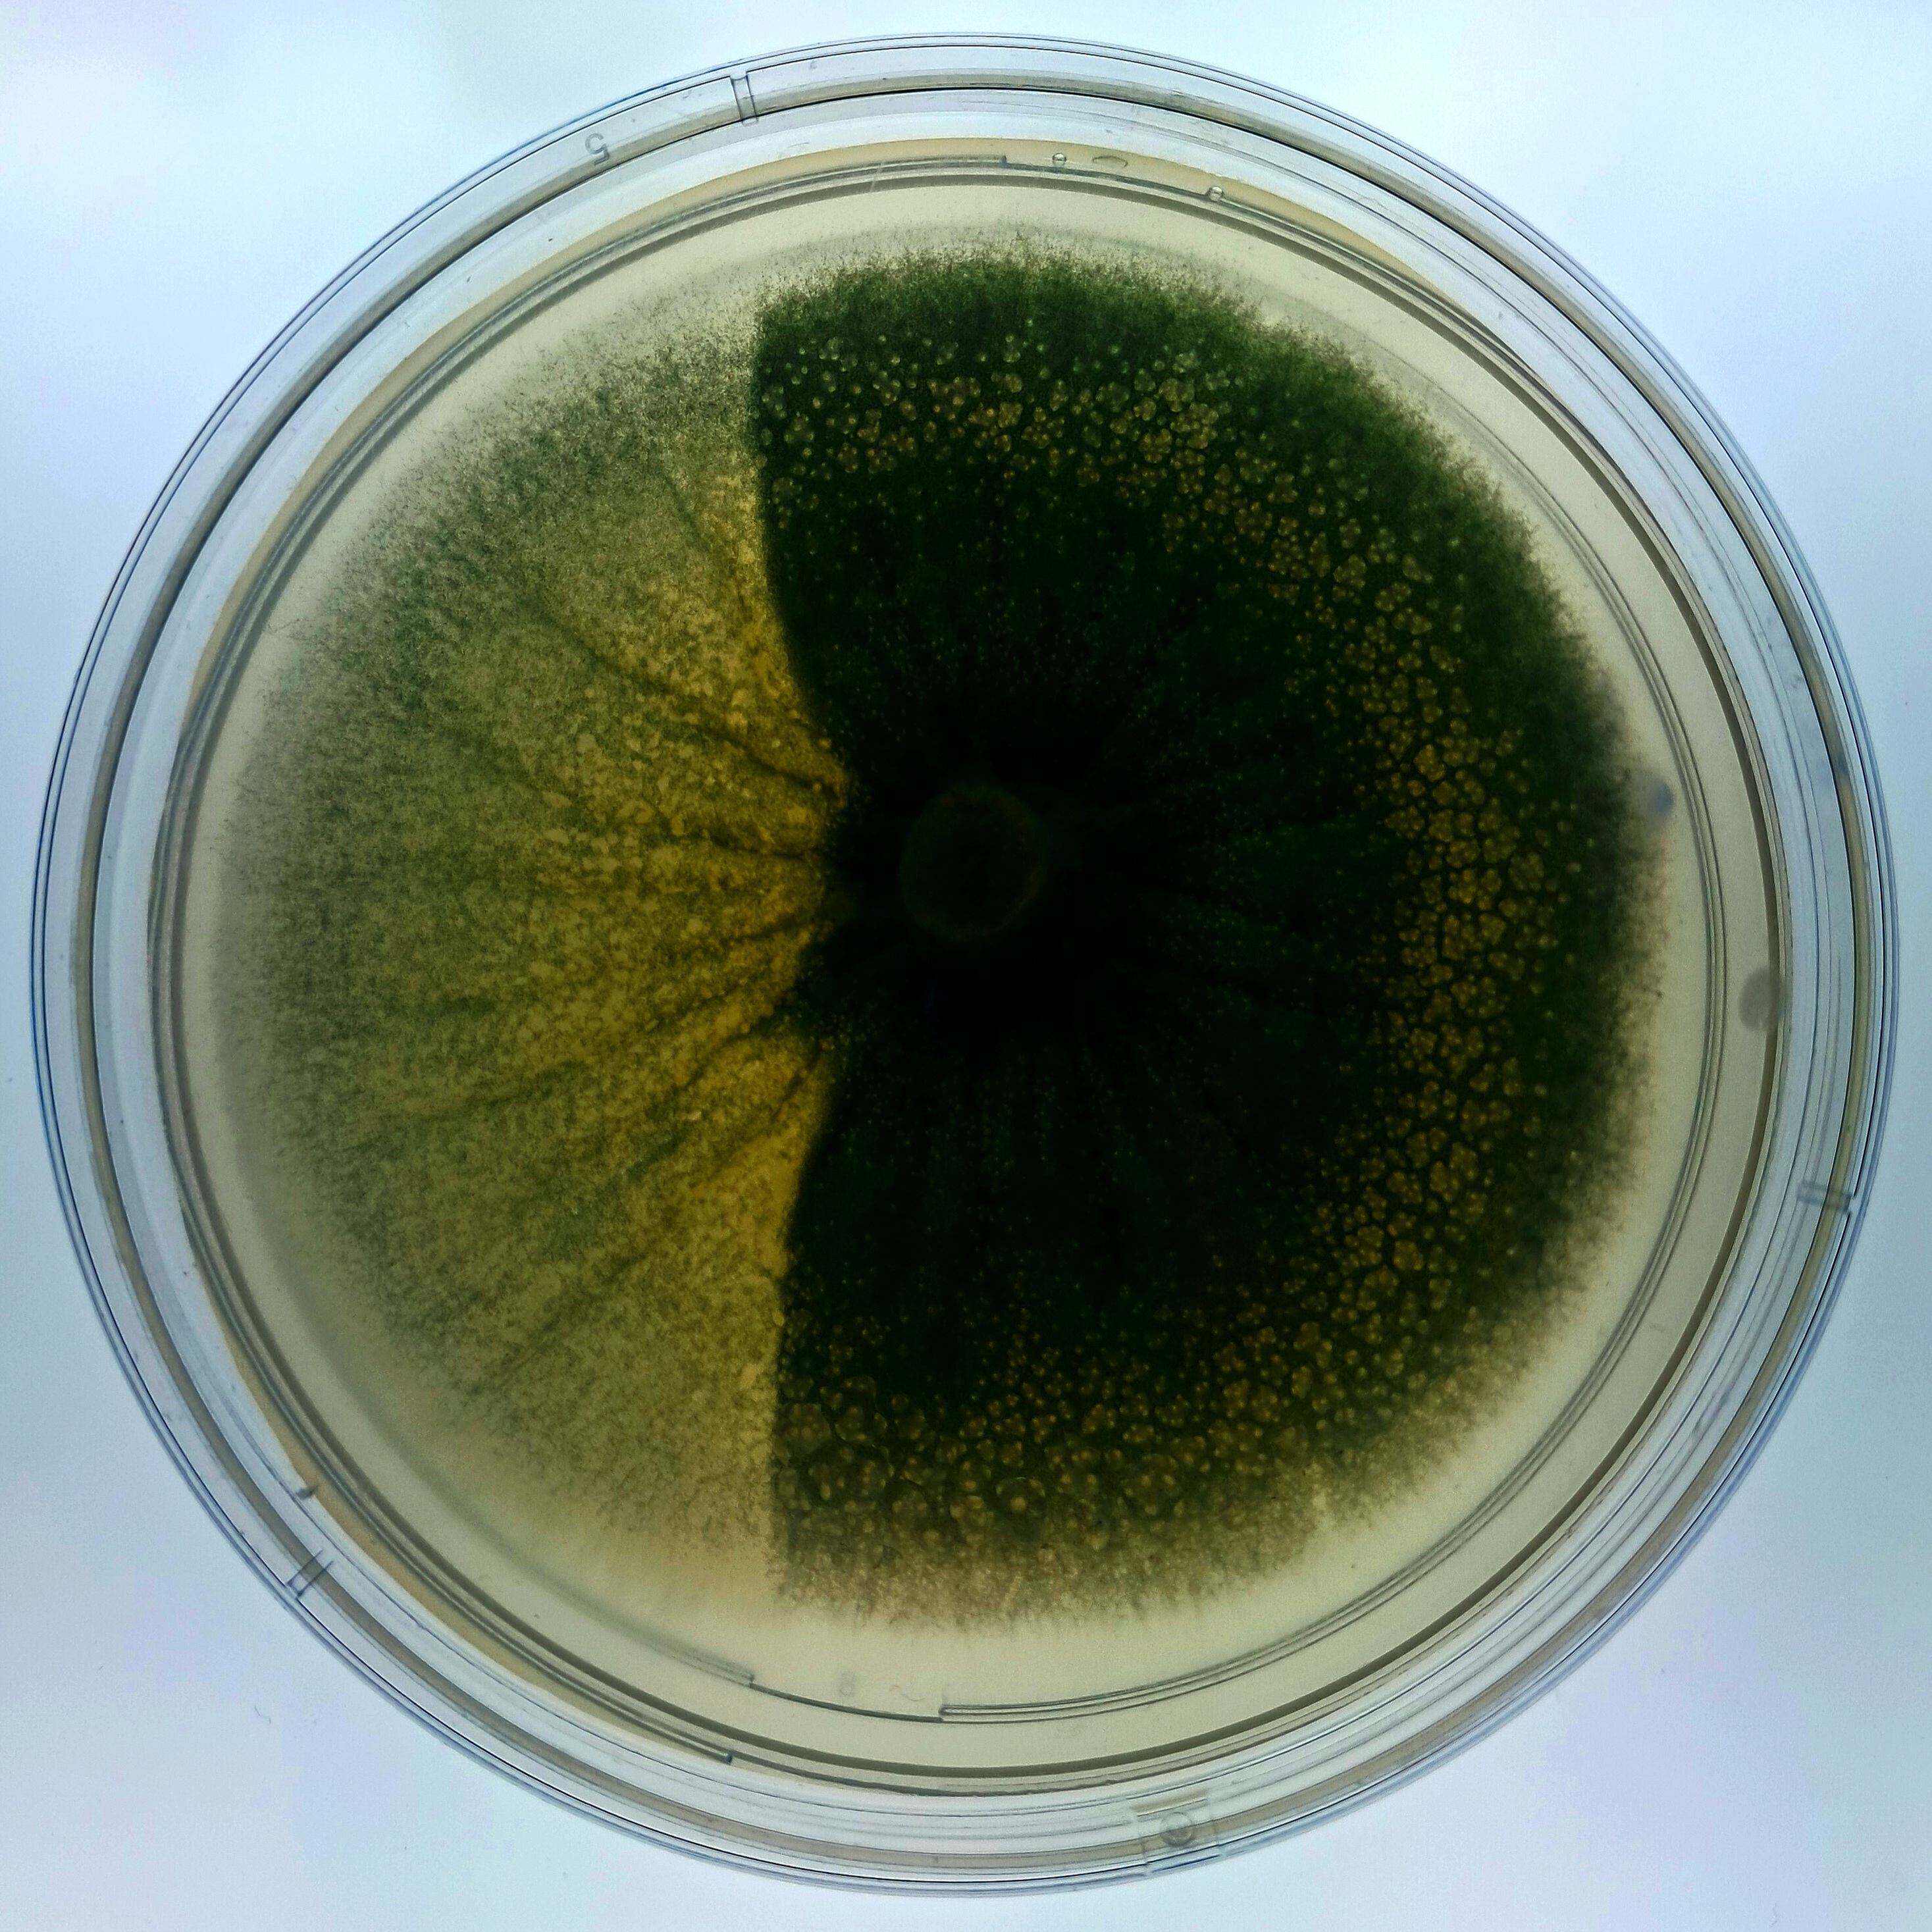

RCB Science Club was envisioned in 2019 under the guidance of Prof. Prasenjit Gucchait, with the aim of fostering the exchange of scientific thoughts and ideas that could be transformed into activities. The overarching goal is to use outreach efforts to highlight the potential of biosciences in enhancing the quality of life for all living beings

| Category | Members |
|---|---|
| President | Mr. Shivam Aggarwal |
| Vice President | Ms. Shivani Sharma |
| Magazine Editor | Ms. Neha Guliya |
| Current Members | Mr. Abid, Ms. Anupama, Ms. Bharti, Ms. Bhavya, Mr. Habibi Venki, Ms. Ifrah, Ms. Isha, Mr. Lailesh, Ms. Lishika, Ms. Rutuja Pawar |
| Mentors | Dr. Rajendra Motiani, Dr. Prashant Pawar |
| Office Coordinator | Dr. Nidhi Sharma |
| Past Members | Mr. Abhaydeep Pandey |